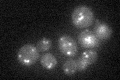
YDR495C

View description
Component of CORVET tethering complex; cytoplasmic protein required for the sorting and processing of soluble vacuolar proteins, acidification of the vacuolar lumen, and assembly of the vacuolar H+-ATPase
Localization:
Intensity:
Fold change:
Significance:
-
C’ GFP library in SD
punctate22.86 -
N' NOP1pr-GFP in SD

punctate50.4136 -
N' TEF2pr-mCherry in SD

cytosol,punctate31.7753 -
N' NATIVEpr-GFP in SD

punctate25.4739 -
N' TEF2pr-VC and Cyto-VN in SD

cytosol,punctate36.9168 -
C’ GFP library in SD+DTT

punctate21.560.94No -
C’ GFP library in SD+H2O2

punctate24.041.05No -
C’ GFP library in Starvation Media

punctate23.731.03No -
C’ GFP library on the background of Pup2-DaMP

punctate -
C’ GFP library on the background of CCT mutant

punctate23.27471.01794No
